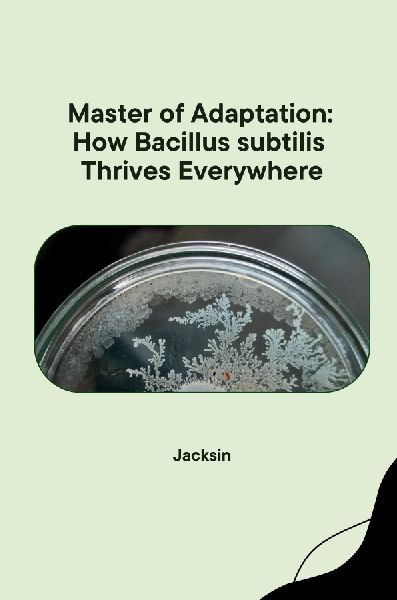

Master of Adaptation: How Bacillus subtilis Thrives Everywhere
This book likely explores the bacterium Bacillus subtilis, a microorganism known for its remarkable ability to adapt and survive in diverse environments. The title "Master of Adaptation" suggests the book delves into the mechanisms Bacillus subtilis uses to thrive everywhere, from extreme temperatures to harsh chemicals. It might explore its unique genetic makeup, its ability to form protective spores, or its efficient use of resources. The book could be aimed at scientists studying bacterial adaptation or at a general audience interested in the wonders of the microbial world (lib)
Mehr anzeigenSofort verfügbar, Lieferzeit: 1-3 Tage
Nur noch wenige Artikel verfügbar!
Weitere Infos zum Zustand
23,89 €
Preise inkl. MwSt. zzgl. Versandkosten
14 Tage Zufriedenheitsgarantie
Risikofrei bestellen
Geprüfte Gebrauchtware
Einzeln geprüft
Produktinformationen "Master of Adaptation: How Bacillus subtilis Thrives Everywhere"
Anmelden
Versandkostenfrei ab 29 €
14 Tage Rückgaberecht - Kein Risiko
Geprüfte Gebrauchtware